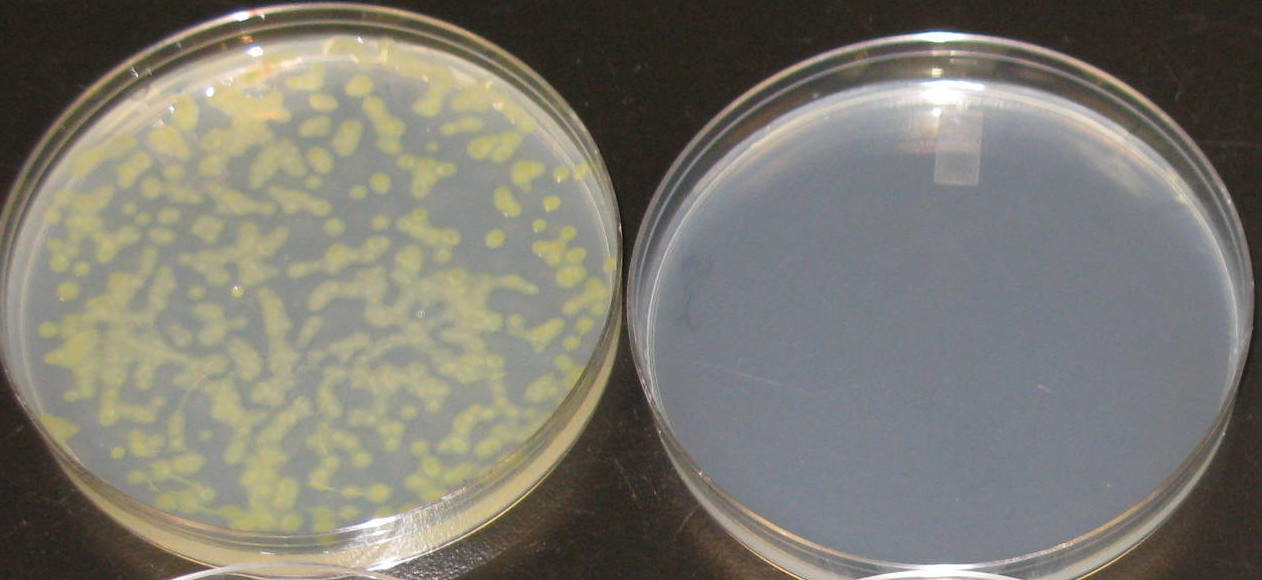

Using Magnesium Oxide Nanomaterial as A Novel Tool for Bacterial Disease Management
Published in Microbiology
Bacterial spot disease of tomato, incited by four Xanthomonas species, is one of the most devastating bacterial diseases on tomato worldwide. The disease causes lesions on leaves (Fig. 1), stems, and fruits1.

As a plant pathologist, I am often amazed by the extent of disease and the variety of symptoms on plants in grower’s fields. For bacterial spot disease of tomato, the most destructive symptom is the extensive blighting or defoliation, which you can see in Fig. 2 where the foliage in lower canopy is completely dead. I have observed these symptoms in tomato field trials that were inoculated with X. perforans, the causal agent of bacterial spot. Defoliation can directly affect fruit yield by affecting fruit size or it can lead to fruit being exposed to excessive sun exposure that can result in sunscald damage to the fruit which directly affects fruit quality. Therefore, bacterial spot disease of tomato can lead to major yield losses and growers long for an effective management strategy all over the world. For many years, tomato growers have used commercial Cu bactericides (up to 500 µg/ml of metallic Cu concentration/up to 2 times a week). One of the main reasons that bacterial spot disease of tomato is so difficult to control is that the bacterial strains have become tolerant to copper as a result of the extensive use of copper (Fig. 3) Therefore, we often receive questions from tomato growers in grower’s meeting and field days asking for novel and ecologically-friendly management methods as an alternative to Cu bactericides. [For more information about bacterial spot disease of tomato in Florida, USA, please check our outreach publication.]

In order to find an effective alternative to Cu bactericides, we evaluated the antibacterial activity of multiple metal oxide nanoparticles against Cu-tolerant X. perforans in the prior study2.Nanoparticles by definition are materials smaller than or equal to 100 nanometers (nm) 3 and are increasingly being developed for plant disease management4,5. In a prior study2, we demonstrated that magnesium oxide nanoparticle (nano MgO) (US Research Nanomaterials, Inc., Houston, TX, USA) could be effective for bacterial spot disease of tomato disease management. The nano MgO application did not cause potential side effects due to elemental accumulation in the fruit. Although MgO is a recognized as a safe (GRAS) compound 6, the fate of MgO nanoparticles in the environment is still poorly understood 7-10. Due to the potential concerns to the environmental risk of nanoparticles 11-13, comparative studies into the efficacy of micron-size particles for disease control is worthy to be explored given that this approach may be more acceptable under the current EPA regulations in the US 14,15. Unlike nanoparticles, micron-sized particles are considered lower risk to the environment. That is the main reason that led us to this study: Evaluating whether bactericidal activity of magnesium oxide against Xanthomonas perforans and bacterial spot of tomato is particle-size dependent. The key discoveries in this study include 1) the bactericidal activity of magnesium oxide against Cu-tolerant X. perforans, is size dependent under field conditions, and 2) MgO nanoparticles could potentially be an effective alternative to the current grower standard.
Besides the exciting result I would like to share with you in the manuscript, I would also like to show you one of the biggest challenges in my graduate studies: evaluating chemicals for disease management in the field. Our trials frequently face the threat of hurricanes, unexpected outbreaks of non-targeted diseases, and the possibility of the field environment not being optimal for the disease to happen. However, since the ultimate research goal for our study is to develop effective and sustainable disease management strategies for the growers, our little setbacks are the least important compared to the livelihood of the tomato growers. In our current study, with mentoring from my Ph.D advisors Dr. Mathews L. Paret and Dr. Jeffrey B. Jones, I have evaluated formulated Mg nanomaterials in collaboration with Dr. Swadeshmukul Santra at the University of Central Florida, USA. Hopefully we will be able to share with you some more findings regarding the antibacterial activity of Mg nanomaterials in the near future.
References:
1 Jones, J. B., Zitter, T. A., Momol, T. M. & Miller, S. A. Compendium of tomato diseases and pests. (Am Phytopath Society, 2014).
2 Liao, Y. et al. Nano-Magnesium oxide: A novel bactericide against copper-tolerant Xanthomonas perforans causing tomato bacterial spot. Phytopathology (2018).
3 Masciangioli, T. & Zhang, W.-X. Peer reviewed: environmental technologies at the nanoscale. Environmental Science & Technology 37, 102A-108A, doi:10.1021/es0323998 (2003).
4 Mazzaglia, A., Fortunati, E., Kenny, J. M., Torre, L. & Balestra, G. M. Nanomaterials in plant protection. Nanotechnology in Agriculture and Food Science 7, 115-133 (2017).
5 Fortunati, E., Mazzaglia, A. & Balestra, G. M. Sustainable control strategies for plant protection and food packaging sectors by natural substances and novel nanotechnological approaches. Journal of the Science of Food and Agriculture 99, 986-1000 (2019).
6 Clydesdale, F. M. A proposal for the establishment of scientific criteria for health claims for functional foods. Nutrition reviews 55, 413-422 (1997).
7 Ghobadian, M., Nabiuni, M., Parivar, K., Fathi, M. & Pazooki, J. Toxic effects of magnesium oxide nanoparticles on early developmental and larval stages of zebrafish (Danio rerio). Ecotoxicology and environmental safety 122, 260-267 (2015).
8 Neal, A. L. What can be inferred from bacterium–nanoparticle interactions about the potential consequences of environmental exposure to nanoparticles? Ecotoxicology 17, 362 (2008).
9 Gelli, K., Porika, M. & Anreddy, R. N. R. Assessment of pulmonary toxicity of MgO nanoparticles in rats. Environmental toxicology 30, 308-314 (2015).
10 Auffan, M. et al. in Nanoethics and nanotoxicology 325-357 (Springer, 2011).
11 Sun, T. Y., Gottschalk, F., Hungerbuhler, K. & Nowack, B. Comprehensive probabilistic modelling of environmental emissions of engineered nanomaterials. Environmental pollution 185, 69-76, doi:10.1016/j.envpol.2013.10.004 (2014).
12 NSET/NEHI. Quantifying Exposure to Engineered Nanomaterials (QEEN) from Manufactured Products. NNI Publications and Reports (https://www.nano.gov/sites/default/files/pub_resource/qeen_workshop_report_2016.pdf) (2015).
13 Nel, A. E. et al. Understanding biophysicochemical interactions at the nano–bio interface. Nature materials 8, 543 (2009).
14 Choi, J.-Y., Ramachandran, G. & Kandlikar, M. (ACS Publications, 2009). 15 Holdren, J. P., Sunstein, C. R. & Siddiqui, I. A. Memorandum for the Heads of Executive Departments and Agencies: Policy Principles for the US Decision-Making Concerning Regulation and Oversight of Applications of Nanotechnology and Nanomaterials. (2011).
Follow the Topic
-
Scientific Reports
An open access journal publishing original research from across all areas of the natural sciences, psychology, medicine and engineering.
Related Collections
With Collections, you can get published faster and increase your visibility.
Advances in neurodegenerative diseases
Publishing Model: Hybrid
Deadline: Jun 30, 2026
AI for clinical decision-making
Publishing Model: Open Access
Deadline: Jun 23, 2026
Please sign in or register for FREE
If you are a registered user on Research Communities by Springer Nature, please sign in